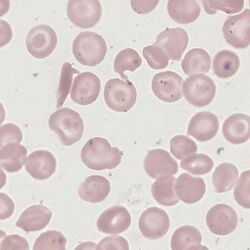

SC poikilocytes
From haematologyetc.co.uk
Derivation: SC = arising in HbSC disease; poikilocyte = irregularly shaped cell
Appearance
A dense and often elongated cell that may resemble a poorly formed sickle cell or an unusually shaped poikilocyte, but is characterised particularly by irregular short branches that project from the cell body.
Showing the typical elongated form with two straight branches, variations on the theme are characteristic (although often rare) in SC disease. Note that they will be accompanied by other diagnostic features such as the typical contracted cells and target cells of HbSC disease.
Significance
These cells are formed when sickle haemoglobin (HbS) is present together with haemoglobin C (HbC) to form a compound heterozygote disorder (HbSC disease)
Pitfalls
Providing the dense elongated shape is recognised with the typical branches, then the cell is distinctive. However, these forms may be uncommon or absent from otherwise typical HbSC. Look also for boat-shaped cells, contracted cells and target cells.
Causes
| Cause |
|---|
| These cells are typical of HbSC disease, but should occur in the appropriate context of target cells and irregularly contracted cells. |
Clinical Examples
Clinical Image 1: SC poikilocyte in the appropriate cellular context - the appearance closely resembles the cell in the main image 1 (above)
Clinical Image 2: A second image from the same case showing a similar branched poikilocyte but with a more rounded cell body
Pathobiology
Both HbS and HbC have altered solubility in their deoxygenated states. In this case the typical elongated cell presumably arises from the formation of long HbS polymers while the reduced solubility and tendency to crystallisation of HbC gives rise to irregular branches.